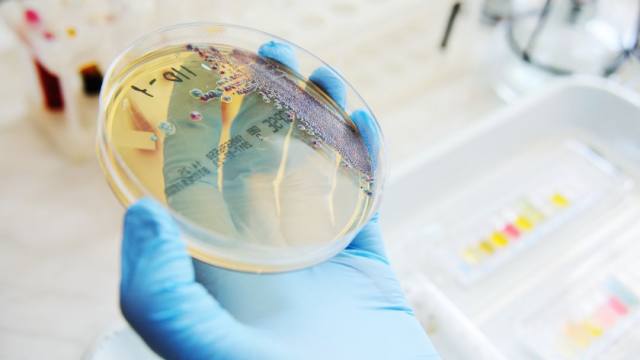
1.jpeg

陆地微生物是否可以在外太空中存活?如果可以的话,它们到底是如何存活下来的?
希望之城的研究者们正在和美国宇航局(NASA)喷气推进实验室(Jet Propulsion Laboratory)进行一系列合作,并着手回答这些问题。从人类健康再到地球生命的起源,他们的发现为一系列问题揭示了新的曙光。
作为与美国宇航局长期合作项目的一部分,该研究由希望之城研究生 Abby Chiang 博士主持、希望之城贝克曼研究所(Beckman Research Institute)质谱与蛋白质组学中心(Mass Spectrometry and Proteomics Core)Markus Kalkum 博士监管。这项研究成果发布于今年 6 月份的美国微生物学会(American Society for Microbiology)上,也正是得益于这项研究所带来的贡献,Chiang 博士被授予了博士学位。
地球上的细菌进入太空,会产生怎样的变化?
该项目最初源自于喷气推进实验室 Kasthuri Venkateswaran 的一项发现。他发现某些细菌菌株(包括短小芽胞杆菌和 horneckiae 芽孢杆菌)具有非常强的耐寒性。它们不仅可以存活在用于建造航天器的无菌室中,即便是暴露在国际空间站外的太空环境中,也依然可以存活。研究还发现,这些耐寒微生物的孢子还能承受过氧化物和紫外线的处理。
「如果未来的太空任务是在他星球上寻找生命,那我们的航天器必须非常洁净。在其他星球上寻找生命的时候,我们不想发现这些生命其实是我们自己带来的。」Kalkum 博士表示。
为了研究微生物在太空中会发生怎样的变化,研究者们把短小芽孢杆菌孢子放入了一个特殊的容器中,并在国际空间站(ISS)外面暴露了 18 个月。
「这些微生物接受了非常极端的挑战——微重力、真空、来自紫外线和短波紫外线的辐射,还有宇宙辐射和粒子辐射。」Chiang 博士表示,「但是当这些孢子被带回地球时,其中一些依然非常活跃。」

孢子是如何在这种极端暴露的环境下存活下来的?
Chiang 博士和 Kalkum 博士使用可以分析分子化合物的结构的质谱分析法和用于蛋白质研究的蛋白质组学对这些孢子进行了分析,这两种技术也可以用于研究癌症生物学机制。然后他们得到了一些有趣的发现:孢子的新陈代谢大大减慢、保护它们的蛋白质外壳变得更大并产生了更强的毒性因子。研究未发现孢子 DNA 的相关变化,这意味着它们所产生的变化可能并不是基因突变。
这些新的信息现在可以帮助科学家开发更有效清洁太空硬件设备的方法。密切地关注空间站上的微生物并了解它们是如何适应微重力的,将继续帮助我们寻找一些有益的方法,来更好的保护宇航员的健康。
同时,该实验也具有其他重要意义。通过了解细菌自我保护和适应环境的机制,我们还可以学习如何增强健康细菌的适应能力,让这些在人体健康中发挥着重要作用的益生菌更好的服务我们。
实际上,Chiang 博士和 Kalkum 博士还参与了一项由国家癌研究所(National Cancer Institute)所支持的益生菌罗伊氏乳杆菌研究。罗伊氏乳杆菌作为一种抑制肠道炎症的细菌菌株,具有辅助治疗结肠癌的潜力。
「益生菌可能很脆弱,」Kalkum 博士表示,「通过研究并利用它们抵抗极端环境的机制,你就有可能让它们变得更强大,就可以通过某些方式,让这些对人类有益的细菌在人体中更好的存活。」
如果美国宇航局希望派遣宇航员去探索月球和火星,那么这些研究将会是至关重要的。
空间站中有的可不仅仅是细菌
在国际空间站上,科研人员所关注的并不仅仅是细菌。科学家们在空间站内部还发现了几种不同的真菌,它们更容易存在于潮湿的表面上。在希望之城与美国宇航局的早期合作中,Chiang 博士和 Kalkum 博士发现,与细菌类似的是,真菌在太空的生存能力要强于它们在地球上的同类。
科学家在国际空间站上发现了一种名为烟曲霉菌的致病菌,相较于其临床对应体 CEA10,空间站中的烟曲霉菌有更强的毒性,作为一种曲霉菌, CEA10 有时会导致免疫抑制患者患病。
它们的自适应机制增强了它们在太空中的存活能力,但是与细菌相反的是,太空中的细菌会减少能量消耗、减缓新陈代谢,但是真菌却会加速它们的新城代谢。一些真菌物种则会产生出黑色素保护层——好像它们在自己生产防晒霜来保护自己。
了解它们的生存机制有助于我们更好的在临床环境中消除它们,在太空中也是如此。因为它们可能会对进行长期任务的宇航员产生危害,这样的研究也有助于帮助机器人探索外星生命。
但是,科学家们在空间站上还发现了一些其他的有益真菌,如青霉素等。
「一些真菌可以对我们带来一些有益的作用,比如用于治疗疾病的抗生素。」Kalkum 博士表示,「因此说在太太空旅行中,科学家们实际上可以利用它们来生产有用的化合物。」
关于地球生命的起源,我们能否从中找到答案?
「你知道胚种假说吗?」Kalkum 博士问道。
「胚种」(Panspermia)是一个希腊词汇,意思是「到处都是种子」,胚种假说认为,源自其他星球的胚种或微生物通过陨石等方式来到地球,并成为地球生命的起源。
「在早期的太阳系中,流星体和小行星要比现在活跃的多得多,如果一些微生物或生物印记可能在太空中旅行并可以存活足够长的时间,它们就可能被带到地球,成为生命的起源。」Kalkum 博士表示,「目前我们没有足够的证据来验证这种假说,但是这项研究为我们提供了这种可能性,因为我们可以看到,其中一些生物非常耐寒而且还能抵御一些极端条件。」
这项研究最初是 Chiang 博士的研究生项目,不仅帮助我们了解了微生物是如何在太空中生存的,在另外一个老掉牙的问题上,更是迈出微小却重要的一步:宇宙中其它地方是否存在生命?
Steven T. Rosen, 医学博士Irell & Manella癌症中心杰出主席教务长和首席科学官希望之城贝克曼研究所所长综合癌症中心主任和教授血液和造血细胞移植科教...
Yuman Fong (方羽满), 医学博士外科主任暨教授、实验治疗学教授国际医学主任、肿瘤外科医师肝癌、胰腺癌、胆囊和胆管专家
Yanghee Woo, 医学博士副教授,肿瘤外科,外科部主任, 肠胃微创治疗计划主任国际外科副主席 肿瘤外科副教授医学博士 Yanghee Woo 是特别训练的外科科学家,其...
Elizabeth Lihua Budde(潘莉华), 医学博士血液科及造血干细胞移植科助理教授血液肿瘤医师Elizabeth Budde 医学博士是 City of Hope 血液学和造血细胞移植...
Stephen J. Forman, 医学博士暨美国内科学会会员 (F.A.C.P.)血液学和造血细胞移植科 Francis & Kathleen McNamara 荣誉主席血液学和造血细胞移...
Larry W. Kwak, 医学博士Toni Stephenson淋巴瘤中心主任转化研究与发展治疗部副主席癌症中心副主任血液和造血干细胞移植科教授
Dan J. Raz, 医学博士、进阶研究博士肺癌与胸腔肿瘤科联合主任外科胸腔部门助理教授胸腔外科医师他经常在部落格发表文章、製作影片和播客,谈论的主题很广,从肺...
Ellie Maghami, 医学博士 Norman 和 Sadie Lee 头颈癌症外科教授头颈外科主席。
Yuan Yuan, 医学博士,博士肿瘤内科及治疗研究部门助理教授医学肿瘤医师